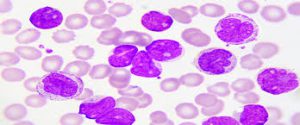

Che cos’è la leucemia acuta
Le leucemie sono un gruppo eterogeneo di neoplasie che originano dalla trasformazione neoplastica di cellule emopoietiche. La cellula bersaglio della trasformazione leucemica può essere rappresentata dalla cellula staminale pluripotente o da elementi immaturi già committed in senso linfoide (LAL) o mieloide (LAM). La popolazione leucemica sostituisce le componenti midollari normali: dalla serie eritroide, mieloide e piastrinopoietica, ne deriva una grave insufficienza funzionale del midollo con passaggio degli elementi neoplastici in periferia.
Differenze tra mielodisplasia e leucemia acuta
La differenza fondamentale tra mielodisplasia e patologia acuta risiede nell’ambito del differenziamento: nelle mielodisplasie, per quanto fortemente compromessa, la differenziazione è presente mentre è assente nelle forme acute. Quindi, il problema fondamentale nelle leucemie acute è il blocco differenziativo che determina un’esposizione di queste cellule, che non si differenziano, ad un sistema segnale dell’ematopoiesi precoce di tipo pro-proliferativo.
Ovviamente nelle leucemie acute, oltre il blocco differenziativo, vi sono una serie di mutazioni che partecipano al processo di trasformazione neoplastica.
Esistono le forme leucopeniche e le forme leucocitosiche o, per meglio dire, iperleucocitosiche.
Conseguenze sul paziente
Il paziente potrà avere:
- Suscettibilità alle infezioni: in particolare si rivolgerà al medico per la febbre persistente;
- Stanchezza;
- Emorragie.
Una o più di queste condizioni rappresentano generalmente il primum movens che porta il paziente a rivolgersi al medico che procede richiedendo un emocromo.
Nomenclatura per la leucemia -acuta
E’ importante inquadrare alcuni termini:
Esordio della leucemia acuta
- Un evento acuto è un evento che si è verificato, da un punto di vista clinico, poco tempo prima che il paziente si rivolgesse al medico. L’esordio dei sintomi è quindi vicino al momento in cui il paziente riceve la diagnosi e in genere si definisce un tempo inferiore a 6 mesi. Il paziente è in grado di dire con precisione quando ha cominciato a stare male.
- Completamente diverso è invece il caso delle malattie croniche. I sintomi e i segni infatti esordiscono prima di 6 mesi dal momento della diagnosi ma il paziente non è in grado di stabilire precisamente quando ha cominciato ad accusare dei problemi perché nella maggior parte dei casi si tratta di sintomi sfumati di modesta entità che descrive in maniera approssimativa.
Decorso della leucemia acuta
Oltre ad indicare l’esordio indicano anche il decorso:
- nel caso dell’acuto è invariabilmente fatale, in un tempo relativamente breve se non trattato;
- nel decorso cronico invece il paziente avrà una sopravvivenza discretamente lunga anche se non trattato, tuttavia in quest’ultimo caso andrà incontro a complicanze che potrebbero causarne l’exitus.
Linea interessata nella leucemia acuta
Bisogna fare una distinzione in base alla linea interessata, ovvero mieloide o linfoide:
- per mieloide si intende tutto ciò che non è linfoide che può quindi essere eritroide, piastrinopoietica, mieloblastica, monoblastica (non va dimenticato che le linee ematopoietiche sono quattro);
- per linfoide viceversa.
Quindi si avranno:
ACUTE: mieloidi (LAM), linfoidi (LAyL).
CRONICHE:
- Mieloproliferative: leucemia mieloide cronica, policitemia vera, trombocitemia essenziale, mielofibrosi idiopatica.
- Linfoproliferative: leucemia linfatica cronica, leucemia prolinfocitica, leucemia a cellula capellute.
Fenomeni infiltrativi/sostitutivi degli organi linfoidi primitivi e/o secondari o extralinfonodali
Le cellule se lasciano il loro sito di origine possono, attraverso il sangue, passare da un organo linfoide primario ad uno secondario o a un organo extralinfonodale: ciò viene definito come infiltrazione.
Se invece la malattia ha esordito nel midollo, non si parla di infiltrazione midollare ma di sostituzione: nella leucemia acuta i blasti sostituiscono il midollo normale e infiltrano per esempio linfonodo, milza, cute e SNC.
La patologia insorge durante l’ematopoiesi precoce, nella cellula staminale uncommited, quindi o totipotente o multipotente, per cui si tratta di precursori ematopoietici precoci (solo qui avviene la trasformazione neoplastica nell’ambito delle leucemie acute o croniche). La conseguenza di questa trasformazione è il blocco differenziativo e il danno sulla funzione ematopoietica a carico di globuli bianchi, emoglobina e piastrine.
Epidemiologia: Le leucemie rappresentano 1/3 di tutti i tumori linfoidi.
Frequenza delle LA:
- 30% dei tumori infantili (tra le forme infantili 65-80% LAL).
- <3% dei tumori dell’età adulta (++ LAM).
Le leucemie acute rappresentano la principale causa di mortalità da cancro nei soggetti <35 anni.
Età di massima incidenza LAM: 50-60 anni.
Età di massima incidenza LAL: 1-9 annni.
Malattie oncoematologiche
- Acute: mieloidi (LAM), Linfoidi (LAL).
- Croniche:
- mieloproliferative: leucemia mieloide cronica, policitemia vera, trombocitemia essenziale, mielofibrosi idiopatica;
- linfoproliferative: leucemia linfatica cronica, leucemia prolinfocitica, leucemia a cellule capellute.
Aspetti clinico-laboratoristici della leucemia acuta
- Infiltrazione midollare: alterazione di una o più linee ematopoietiche, suscettibilità alle infezioni;
- Effetti su altri organi linfoidi: sovvertimento struttura e funzione linfonodi (suscettibilità alle infezioni, fenomeni da compressione), sovvertimento struttura e funzione milza (suscettibilità alle infezioni, fenomeni da compressione, rischio rottura);
- Effetti su organi non linfoidi: infiltrazione organo, danno di funzione, fenomeni da compressione.
Eziologia della leucemia acuta
- Fattori virali: virus a RNA (retrovirus), virus a DNA (herpes virus);
- Fattori genetici: s. di Down, s. di Bloom, s. di Fanconi, s. di Klinefelter, s. di Wiskott-Aldrich, Atassia-Teleangectasia;
- Fattori immunologici: immunodeficienza congenita o acquisita;
- Fattori ambientali: radiazioni ionizzanti, sostanze chimiche (benzene), farmaci (alchilanti, nitrosuree).
Classificazione della leucemia acuta
Classificazione Morfologica FAB
Nel 1982 Francesi, Americani e Britannici hanno definito la prima versione della classificazione FAB.
LAM FAB
- M0: forma indifferenziata (non si è in grado di definirla, di solito è una cellula altamente indifferenziata in cui ci sono pochi elementi che suggeriscono che sia di origine mieloide); CD13, CD33, CD34, HLA-DR, CD117;
- M1: mieloblastica senza maturazione; blasti midollari >90%; CD13, CD33, CD34, HLA-DR, CD117;
- M2: mieloblastica con maturazione; blasti midollari <90%(è la percentuale di blasti che differenzia la M1 e la M2); CD13, CD33, HLA-DR, CD117, CD15;
- M3: promielocitica; caratterizzata dalla presenza dei promielociti (blasti ipergranulati con corpi di Auer); CD13, CD33, CD117, CD15;
- M4: mielomonocitica (livello di maturazione un po’ più avanzato); mieloblasti <80%, monoblasti >20%; CD13, CD33, CD11b, CD14, CD15, CD117;
- M5a: monoblastica senza maturazione; monoblasti >80%, promonociti e monociti <20%;
- CD13, CD33, CD34, CD11b, CD14, CD15, CD117;
- M5b: monoblastica con maturazione; monoblasti <80%, promonociti e monociti >20%;
- CD13, CD33, CD11b, CD14, CD15, CD117;
- M6: eritroblastica; eritroblasti >50%, mieloblasti >30%; CD36, CD71;
- M7: megacarioblastica; blasti di tipo megacarioblastico >30%; CD9, CD36, CD41, CD42a e b, CD61;
M6 ed M7 sono considerate delle forme “speciali”. Nella classificazione delle mieloidi sono presenti tutte e quattro le linee; il motivo per cui si chiamano mieloidi è che dal punto di vista terapeutico si trattano tutte allo stesso modo ad eccezione della M3.
La classificazione morfologica del blasto è caratterizzata da:
- Un elevato rapporto nucleo/citoplasma; in realtà non è sempre così perché dipende dal tipo di classe in questione: questo è vero nella M0 ma non nella monoblastica in cui invece il citoplasma è più rappresentato.
- La cromatina è molto fine; quando invece è granulata e opaca è una cromatina con aspetto normale.
- Il citoplasma può essere più o meno rappresentato a seconda della variante FAB. Al suo interno ci possono essere o meno elementi granulari tipici delle serie mieloidi che non si apprezzano in quelle eritroidi o megacariocitarie oppure ci sono delle forme aberranti di granuli in cui si notano i corpi di Auer (sono sostanzialmente dei granuli che non si sono separati). I corpi di Auer sono un elemento patognomonico della leucemia e sono molto comuni nelle forme M3 (i promielociti producono molti granuli che appaiono come corpi di Auer).
Questi aspetti generali sono tutti evidenziabili con le colorazioni tra le quali quella diMay-Grunwald Giemsa. Le colorazioni citochimiche servono ad evidenziare attività enzimatiche intracellulari come quella della mieloperossidasi, enzima delle cellule mieloidi e non delle linfoidi (è presente nei granuli). La classificazione FAB delle linfoblastiche presenta solo 3 sottotipi;
LAL FAB
- L1: Blasti di piccole dimensioni, scarso citoplasma, più frequente nel bambino;
- L2: Blasti grandi ed eterogenei con uno o più nucleoli, più frequente nell’adulto;
- L3: Blasti vacuolati iperbasofili con nucleoli e vacuoli nucleari.
Nonostante la potenza diagnostica della FAB, oggi essa non è sufficiente ma bisogna procedere eseguendo la classificazione immunofenotica e la citogenetica e molecolare.
Classificazione Immunofenotipica:
L’immunofenotipica, attraverso l’utilizzo di anticorpi monoclonali, identifica i cluster di differenziamento determinando l’immunofenotipo cellulare. Nell’ematopoiesi normale si ha un cambiamento dell’immunofenotipo durante la differenziazione, per cui i marcatori espressi nell’ematopoiesi precoce non saranno presenti in quella tardiva e viceversa. Ovviamente alcuni vengono conservati: sono i marcatori di lineage che identificano cioè la linea di appartenenza. Alcuni marcatori sono presenti in alcune forme di leucemia ma non in altre.
ü Il CD34 è un tipico marcatore di immaturità, non a caso si trova espresso soprattutto dai blasti delle leucemie acute indifferenziate; ad esempio non è presente in M5b o la M4, ma è espresso in M5a.
ü Un’altra caratteristica della serie mieloide (serie e non patologia mieloide) è l’espressione del CD13 e delCD33 che indicano, appunto, l’origine mieloide (non sono presenti nell’eritroblastica o nella megacarioblastica). In una cellula blastica molto indifferenziata, in cui non è chiaro che si tratti di un linfoblasto o un mieloblasto, si può stabilire se con l’immunofenotipica si ritrova il CD13 o il CD33 (sarà in tal caso mieloide).
ü Ci sono dei marcatori presenti anche nelle cellule normali. CD14 è un tipico marcatore dei monociti (non macrofagi), si riscontra nelle mielomonocitiche, nelle monoblastiche con o senza maturazione. Quindi, molti marcatori di lineage normale si ritrovano nei lineage patologici in combinazione però con marcatori che nelle cellule normali non dovrebbero essere presenti. Per esempio CD34, CD13 e CD33 insieme al CD14 non si trovano su un monoblasto normale ma solo su uno patologico.
La classificazione immunofenotipica quantifica meglio anche il numero di blasti. Per cui è fondamentale per la diagnosi iniziale in caso di sospetto di leucemia acuta. Oggi però queste due classificazioni, la FAB e l’immunofenotipica, non sono più sufficienti perché ciò che è davvero importante nelle leucemie acute, che ha reale impatto sulla prognosi, è la lesione molecolare.
Ecco quindi che nasce la classificazione basata sulla citogenetica e sulle lesioni molecolari.
Classificazione Citogenetica e molecolare
Nell’ambito della citogenetica sono presenti metodiche standard convenzionali e altre metodiche come la FISH. Quest’ultima si basa sull’utilizzo di sonde costituite da DNA a sequenza nota, marcate, con le quali si va a ricercare la presenza di una determinata sequenza sul cromosoma.
Differenze con la citogenetica convenzionale, ovvero con il bandeggio cromosomico:
- Innanzitutto con la FISH si identificano lesioni che sfuggono con il bandeggio;
- La seconda differenza è di tipo tecnico: infatti per fare il bandeggio cromosomico è necessario un prelievo di leucociti dal sangue periferico; successivamente devono essere messi in coltura per poi essere bloccati in metafase. Nella FISH invece le cellule devono essere bloccate in interfase.
Alterazioni citogenetiche tipiche delle leucemie acute. In particolare nelle LAM:
- M2 à t(8;21),
- M3 à t(15;17),
- M4 à inv 16,
- M5 à t(9;11),
- M1, M2, M4 à t(6;9),
- non specifiche: trisomia 8, 21; delezioni o monosomia 7.
Ci sono delle situazioni particolari che vengono considerata a parte, come la leucemia acuta associata a sindrome di Down, ovvero a trisomia 21, oppure si possono avere leucemie acute con mielodisplasia, leucemie acute secondarie, che sono peggiori delle acute de novo.
Dal punto di vista molecolare si distinguono:
- lesioni in grado di arrestare il processo differenziativo: traslocazioni come PML-RARα;
- lesioni in gradi di conferire vantaggio proliferativo: coinvolgono protooncogeni comuni come Ras, FLT3, JAK2, BCR-ABL.
Lesioni epigenetiche
Esiste poi una terza categoria, oggi estremamente rilevante sia nelle mielodisplasie che nelle leucemie acute, che è quella delle lesioni epigenetiche. Il controllo epigenetico consiste in variazioni della conformazione cromatinica del DNA determinate da metilazioni o deacetilazioni degli istoni che provocano una riduzione o un aumento dell’espressione del DNA. Interferendo sul controllo epigenetico si può attivare o deprimere l’espressione genica ed è proprio in questo modo che avvengono i blocchi differenziativi, ovvero deprimendo l’espressione di geni coinvolti nella differenziazione.
Se si tratta di neoplasie altamente indifferenziate le lesioni dei pathway tipici coinvolti nel self-renewal possono essere importanti. La disseminazione è invece legata ad alcune varianti di leucemie acute che acquisiscono delle proprietà che non necessariamente altre varianti presentano.
FLT3
FLT3 è particolarmente importante perché è mutato in 1/3 delle leucemie mieloidi. La maggior parte delle mutazioni di FLT3 provocano una attivazione costitutiva, per cui non necessita del ligando per funzionare. Se viene mutato in dei modelli murini si ottiene una sindrome mieloproliferativa, ovvero i globuli bianchi proliferano in maniera incontrollata. E’ importante ricordare il pathway di FLT3 perché coinvolge il pathway delle MAP-chinasi, delle PI3K e di mTor che sono comuni nell’oncogenesi.
T (15;17)
Bisogna intendere la traslocazione come un evento che avviene tra due porzioni geniche costituite da un segmento regolatore e un segmento codificante da cui si forma un gene di fusione con la porzione regolatoria di uno dei due, mentre l’altro si perde. Il risultato è un gene ibrido e una proteina chimerica.
Questo avviene più frequentemente nella LAM.
La t(15;17) è l’esempio paradigmatico di questa condizione. Il partner più comune del cromosoma 17 (recettore dell’acido retinoico, RARα) è il cromosoma 15 ma in realtà ci sono altre varianti che danno origine sempre alla stessa leucemia, ovvero la leucemia promielocitica acuta, come le t(11;17) e t(17;17). Il promielocita è ricco di granuli contenenti enzimi quali proteasi e idrolasi. Questi presenti nei promielociti blastici, invece di rappresentare il 5% della filiera ematopoietica, diventano il 70%, essendo poi rilasciati dai promielociti provocano di conseguenza coagulazione intravascolare disseminata CID.
Il cromosoma 17 è tagliato a livello del braccio lungo del q21 e contiene il gene che codifica per il recettore dell’acido retinoico, RARα. Questo gene è sempre traslocato. Nel 90% dei casi il partner è 15q22 che contiene un gene che si chiama PML (promyelocytic leukemia). L’acido retinoico ha un ruolo molto importante dal punto di vista embriologico perché è un morfogeno che determina un gradiente differenziativo ed è coinvolto nella polarizzazione dell’embrione. Nell’ematopoiesi fa parte di un complesso macromolecolare che contiene RXR e un corepressore che si legano ai RARE (elementi responsivi dell’acido retinoico).
Tuttavia oltre alla t (15;17) ci sono delle alterazioni mutageniche addizionali che partecipano alla determinazione della leucemia che vanno combattute con la chemioterapia e che l’acido retinoico non è in grado di contrastare. Quindi generalmente si utilizza l’ATRA (Acido Retinoico tutto-trans) in associazione alla chemioterapia; l’ATRA va cominciata immediatamente in un paziente con leucemia promielocitica perchè va a bloccare immediatamente la CID.
Nella t(8;21) i partner sono AML-1 ETO e, anche qui, a causa di una proteina aberrante si determina il blocco della trascrizione.
Riconoscere la traslocazione presente in una determinata forma leucemica è importante soprattutto dal punto di vista prognostico.
Diagnosi per leucemia acuta
- Esame emocromocitometrico con formula leucocitaria (anemia, leucocitosi, piastrinopenia, blasti nella formula);
- Esame morfologico con colorazione May-Grunwald del sangue periferico e del midollo;
- Colorazione citochimica dei blasti leucemici: PAS, P.A. Sudan Nero, mieloperossidasi;
- Studio dell’immunofenotipo con Ab monoclonali;
- Analisi citogenetica (convenzionale e FISH);
- Analisi molecolare (tecniche di PCR).
Sintomi per leucemia acuta
- Astenia legata soprattutto all’anemia, alla possibilità che ci sia febbre persistente;
- Calo ponderale;
- Emorragia;
- Dolori addominali;
- Dolori osseilegati alla funzione midollare,
- Sintomi neurologici: vi è l’invasione del sistema nervoso centrale da parte dei blasti soprattutto attraverso le meningi (caratteristica delle leucemie linfoblastiche acute). Una delle prime cose che si fa infatti quando si diagnostica una leucemia linfoblastica acuta è la puntura lombare che ha due funzioni:
- diagnostica perchè la meningosi leucemica potrebbe essere già in atto;
- se c’è già la meningosi si inietta farmaco a scopo terapeutico, se non è gia in atto si inietta comunque a scopo profilattico per impedire che cellule neoplastiche entrino nel liquido cefalorachidiano. Nelle linfoblastiche questa procedura si deve fare sempre mentre nelle mieloidi si deve fare solo nelle forme iperleucocitosiche.
Segni di leucemia acuta
- Se c’è infiltrazione di organi come fegato o milza si avrà epatomegalia o splenomegalia;
- Si può avere anche infiltrazione extralinfoide come cutanea e gengivale (soprattutto M4 e M5): infiltrazione cutanea e ipertrofia gengivale;
- Mediastino allargato.
Esiste anche la possibilità di avere delle forme ad espressione mista, anche chiamate leucemie acute bifenotipiche o ibride in cui vi sono sia marcatori immunofenotipici della serie mieloide che della serie linfoide. Queste forme hanno una prognosi peggiore.
- Leucemia acute con espressione fenotipiche miste linfoidi e mielodi (CD13, CD14, CD33, CD43, CD19, CD2, CD7);
- Gli antigeni di linea linfoidi e mieloidi possono essere espressi sulla stessa cellula o contemporaneamente su blasti differenti.
Fattori prognostici sfavorevoli LAM
- Età avanzata;
- Compromissione o insufficienza di organi o apparati (fegato, reni, cuore, apparato respiratorio);
- Citotipo FAB: M0, M5, M6, M7;
- Immunofenotipo: L. bifenotipiche.
Fattori prognostici sfavorevoli LAL
- Età: meno di un anno o più di nove;
- Localizzazione: mediastinica e al SNC;
- Sesso: maschile;
- Leucocitosi >35.000/mmc;
- Citotipo FAB: L3;
- LDH sierico elevato;
- Forma bifenotipica;
- Fenotipo B;
- Presenza del cromosoma Philadelphia.
Terapia remissione completa della LA si ha quando ci sono
- scomparsa dei segni e dei sintomiche contraddistinguevano la malattia all’esordio clinico,
- normalizzazione dell’emocromo,
- normalizzazione della quota blastica midollare (inferiore al 5%).
Se invece: è la quota blastica diminuisce si continua la terapia, è se ciò non avviene, vi è una elevata probabilità che il paziente non risponda alla terapia. In questo modo è possibile cambiare terapia qualora quella precedente non dovesse funzionare. In ematologia qualunque remissione inferiore a quella completa viene considerata come fallimento.
Dopo aver ottenuto una remissione completa solitamente si fa un altro trattamento: la terapia di consolidamento.
L’approccio alla leucemia acuta mieloide e quella linfoblastica è differente.
Nelle leucemie mieloidi acute si fa un ciclo di induzione;
- se il paziente è in remissione facciamo un ciclo di consolidamento;
- se il paziente ha un’età fino ai 60 anni ed ha un donatore compatibile, si sceglie il trapianto di midollo allogenico.
Nelle leucemie linfoblastiche acute si usano dei protocolli che sono stati sviluppati nella cura della leucemia sul bambino, poiché quest’ultime sono le prime leucemie ad essere state curate.
Sul bambino la terapia è più aggressiva perché:
- il bambino ha una resistenza alla chemioterapia completamente diversa da quella dell’adulto;
- nel bambino vogliamo cercare di perseguire la guarigione a tutti i costi.
Generalmente lo schema classico, anche se ci sono variazioni sul tema, è dato da: cicli ripetuti di induzione seguiti da alcuni cicli di mantenimento.
La terapia classica della leucemia linfoblastica acuta dura più o meno 3 anni: per 1 anno circa si fa la terapia ad induzione continua, per altri 2 anni si fa una terapia di mantenimento con dei chemioterapici meno aggressivi.
Il trapianto è previsto solo se la malattia recidiva. L’allogenico si fa sia nelle recidive ma anche in situazioni particolari ovvero fattori prognostici molto negativi, primo su tutti la presenza del cromosoma philadelphia.
Leucemia acuta: terapia di supporto
- Anemia: trasfusione di globuli rossi concentrati.
- Infezioni: isolamento del paziente, provvedimenti igienici ed ambientali, sorveglianza microbiologica, polichemioterapia antibiotica ed antimicotica, fattori di crescita ematopoietici.
- Emorragie: trasfusione di piastrine.
Allopurinolo, urato-ossidasi, iperidratazione controllate e bicarbonati per acidificare le urine al fine di proteggere l’apparato escretore dall’aumento di acido urico in corso che di terapia antitumorale.
Leucemia acuta: remissione completa
- Presenza di blasti leucemici < o = al 5% della cellularità totale, ricostituzione della ematopoiesi normale (almeno 1500 neutrofili e 100.000 piastrine per uL).
- Assenza di cellula blastiche nel sangue periferico.
- Non segni di malattia extramidollare.
Tale condizione deve essere mantenuta per almeno 4 settimane.

